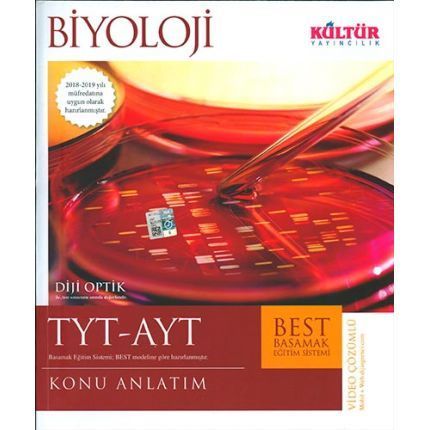

TYT AYT Biyoloji Konu Anlatım Kültür Yayıncılık
%30indirim
69,00 TL
48,30 TL
6,28 TL den başlayan taksitlerle!
TYT AYT Biyoloji Konu Anlatım Kültür Yayıncılık
Bu ürüne ilk yorumu siz yapın!